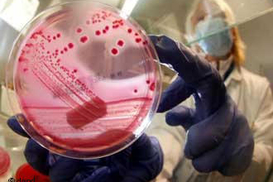
Кишечная палочка убила уже 47 человек в Европе

Инфекция
Некоторые убивают почти в 100% случаев: названы самые смертоносные вирусы
Большинство опасных патогенов передаются человеку от животных и требуют немедленного медицинского вмешательства.
Украина ввела ограничения на ввоз грузов из Венгрии: в чем причина
Госпродпотребслужба ввела запрет на ввоз в Украину из Венгрии определенных категорий грузов.
Румыния ужесточает правила для въезжающих в страну
Власти страны планируют с 20 декабря ввести для румын формы местонахождения пассажира.
Инфляция в Украине: Нацбанк спрогнозировал рост цен до конца года
В НБУ ожидают, что до конца 2021-го продукты продолжат дорожать, но не так стремительно как сейчас.
Пасхальная корзина в Украине подорожала на 10% - Инфографика
Больше всего подорожала пасхальная выпечка.
Вакцины для плановых прививок прибыли в Украину, - Минздрав
Около 3 млн. вакцин от коклюша, столбняка и других инфекций прибыли в Украину.
Медсправка в детский сад: В каких случаях она не нужна
Если ребенок не болен, а пропустил сад по другим причинам,медицинскую справку предоставлять не нужно.